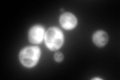
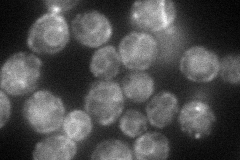
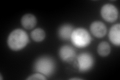

View description
Saccharopine dehydrogenase (NADP+, L-glutamate-forming); catalyzes the formation of saccharopine from alpha-aminoadipate 6-semialdehyde, the seventh step in lysine biosynthesis pathway; exhibits genetic and physical interactions with TRM112
Localization:
Intensity:
Fold change:
Significance:
-
C’ GFP library in SD
cytosol868.79 -
N' NOP1pr-GFP in SD
cell periphery,ER65.7365 -
N' TEF2pr-mCherry in SD

cell periphery,vacuole15.9715 -
N' NATIVEpr-GFP in SD

below threshold18.3668 -
N' TEF2pr-VC and Cyto-VN in SD

#N/A0 -
C’ GFP library in SD+DTT
cytosol826.140.95No -
C’ GFP library in SD+H2O2

cytosol1206.731.38No -
C’ GFP library in Starvation Media

nucleus, cytosolN/AN/AYes -
C’ GFP library on the background of Pup2-DaMP

cytosol -
C’ GFP library on the background of CCT mutant

cytosol1007.681.15985No
